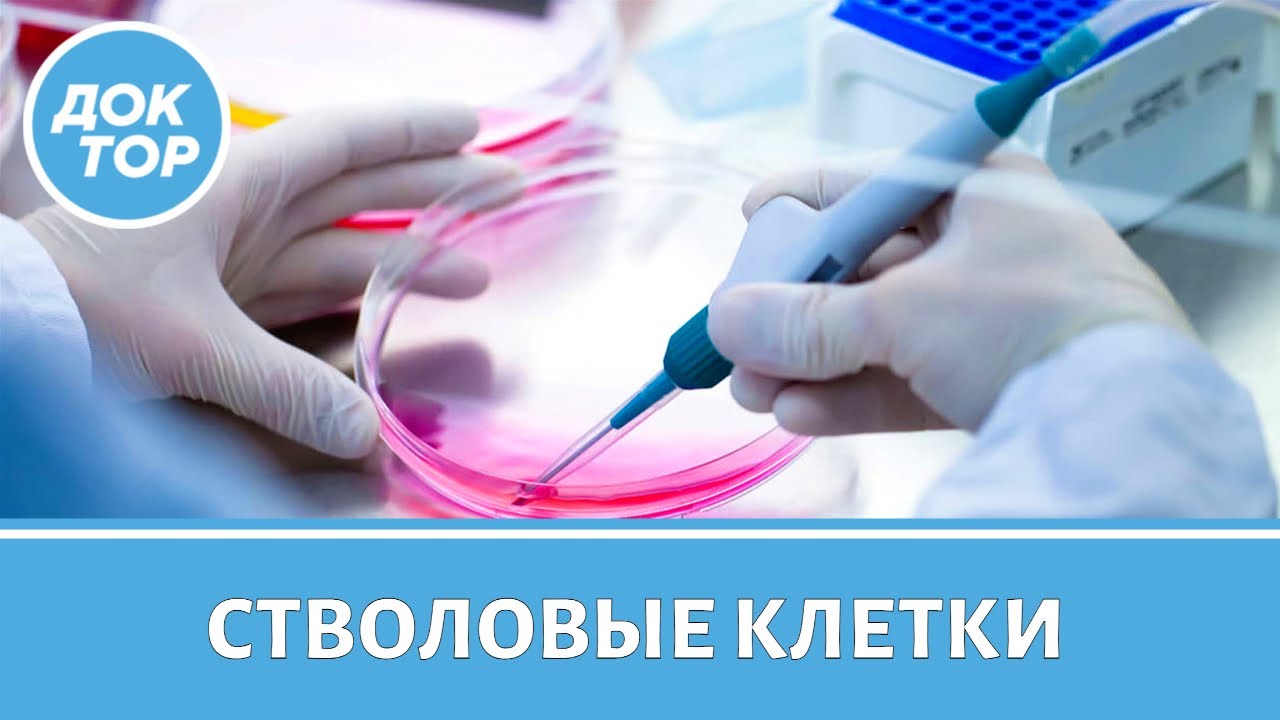
ЗА и ПРОТИВ лечения стволовыми клетками

Fox News Highlights - April 27th, 2026
Laura Ingraham, Jesse Watters, Sean Hannity and Greg Gutfeld bring Fox News viewers their fresh takes on the top news of the day. #fox #media #breakingnews #us #usa #new #news #breaking #foxnews #jessewattersprimetime #jessewatters #politics #political #politicalnews #government #democrats #democraticparty #democrat #crime #crimenews #crimestory #criminal #police #violence #washingtondc #washington #dc #whitehouse #shooting #security #law #publicsafety #lauraingraham #seanhannity #greggutfeld #commentary #opinion #primetime #television #broadcast #dailynews #analysis #topstories #headlines #montage #mashup #highlights #recap #monologueDon’t just watch Fox News—be part of it. Become a Fox News Patriot today. https://youtube.com/foxnews/join
Subscribe to Fox News: https://bit.ly/2vBUvAS
Watch more Fox News Video: http://video.foxnews.com
Watch Fox News Channel Live: http://www.foxnewsgo.com/
Download the Fox News app: https://foxnews.onelink.me/xLDS/cd5yhg3o
FOX News Channel (FNC) is a 24-hour all-encompassing news service delivering breaking news as well as political and business news. The number one network in cable, FNC has been the most-watched television news channel for 18 consecutive years. According to a 2020 Brand Keys Consumer Loyalty Engagement Index report, FOX News is the top brand in the country for morning and evening news coverage. A 2019 Suffolk University poll named FOX News as the most trusted source for television news or commentary, while a 2019 Brand Keys Emotion Engagement Analysis survey found that FOX News was the most trusted cable news brand. A 2017 Gallup/Knight Foundation survey also found that among Americans who could name an objective news source, FOX News was the top-cited outlet. Owned by FOX Corporation, FNC is available in nearly 90 million homes and dominates the cable news landscape, routinely notching the top ten programs in the genre.
Watch full episodes of your favorite shows
The Five: https://www.foxnews.com/video/shows/the-five
Special Report with Bret Baier: https://www.foxnews.com/video/shows/special-report
Jesse Watters Primetime: https://www.foxnews.com/video/shows/jesse-watters-primetime
Hannity: https://www.foxnews.com/video/shows/hannity
The Ingraham Angle: https://www.foxnews.com/video/shows/ingraham-angle
Gutfeld!: https://www.foxnews.com/video/shows/gutfeld
Fox News @ Night: https://www.foxnews.com/video/shows/fox-news-night
Follow Fox News on Facebook: https://www.facebook.com/FoxNews/
Follow Fox News on X: https://x.com/foxnews
Follow Fox News on Instagram: https://www.instagram.com/foxnews/ Receive SMS online on sms24.me
TubeReader video aggregator is a website that collects and organizes online videos from the YouTube source. Video aggregation is done for different purposes, and TubeReader take different approaches to achieve their purpose.
Our try to collect videos of high quality or interest for visitors to view; the collection may be made by editors or may be based on community votes.
Another method is to base the collection on those videos most viewed, either at the aggregator site or at various popular video hosting sites.
TubeReader site exists to allow users to collect their own sets of videos, for personal use as well as for browsing and viewing by others; TubeReader can develop online communities around video sharing.
Our site allow users to create a personalized video playlist, for personal use as well as for browsing and viewing by others.
@YouTubeReaderBot allows you to subscribe to Youtube channels.
By using @YouTubeReaderBot Bot you agree with YouTube Terms of Service.
Use the @YouTubeReaderBot telegram bot to be the first to be notified when new videos are released on your favorite channels.
Look for new videos or channels and share them with your friends.
You can start using our bot from this video, subscribe now to Fox News Highlights - April 27th, 2026
What is YouTube?
YouTube is a free video sharing website that makes it easy to watch online videos. You can even create and upload your own videos to share with others. Originally created in 2005, YouTube is now one of the most popular sites on the Web, with visitors watching around 6 billion hours of video every month.